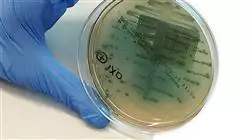
##IMAGE##

Qualificação universitária
A maior faculdade de medicina do mundo”
Porquê estudar no TECH?
Você irá identificar com eficiência os fatores de risco cardiovascular para promover o diagnóstico precoce, tudo graças a este avançado programa 100% online”
A doença arterial periférica é uma doença crônica que afeta os vasos sanguíneos que fornecem sangue às extremidades. Essa patologia é comumente associada a fatores de risco, como tabagismo, diabetes e colesterol alto. Diante de sintomas importantes, como claudicação intermitente, perda de massa muscular ou alterações na pele, os especialistas precisam aplicar os tratamentos mais modernos para gerenciar e acompanhar, com o objetivo de melhorar a qualidade de vida dos indivíduos.
Para ajudá-los nessa atualização, a TECH implementou um curso que otimizará a intervenção no tratamento de distúrbios cardiorrespiratórios. Elaborado por um corpo docente experiente, o currículo se concentrará em doenças de longo prazo, incluindo dislipidemia e apneia obstrutiva do sono.
Nesse sentido, o programa de estudos se aprofundará na abordagem das patologias, levando em conta fatores como dieta, repercussões orgânicas e até mesmo novos tratamentos com o uso de farmacologia inovadora, que foram desenvolvidos recentemente. Além disso, será dada ênfase a como os profissionais podem aprimorar o gerenciamento de casos difíceis, usando tecnologia de ponta e registros médicos computadorizados.
Para consolidar esses conteúdos, a metodologia deste programa reforça seu caráter inovador. A TECH oferecerá um ambiente educacional 100% online, onde o único requisito é que os alunos tenham um dispositivo eletrônico com acesso à Internet para expandir seus conhecimentos e adquirir novas habilidades para enriquecer sua prática clínica.
Ele também emprega a revolucionária metodologia Relearning, baseada na repetição de conceitos fundamentais para fixar o conhecimento e facilitar a aprendizagem. Assim, a combinação de flexibilidade e uma abordagem pedagógica robusta o torna altamente acessível.
Você realizará o monitoramento mais preciso do Cor Pulmonale, ajustando as terapias e otimizando os resultados”
Este Curso de Patologias Cardiorrespiratórias no Paciente Crônico Complexo conta com o conteúdo científico mais completo e atualizado do mercado. Suas principais características são:
- O desenvolvimento de casos práticos apresentados por especialistas no Paciente Crônica Complexo
- O conteúdo gráfico, esquemático e extremamente útil, fornece informações científicas e práticas sobre as disciplinas essenciais para o exercício da profissão
- Exercícios práticos em que o processo de autoavaliação é realizado para melhorar a aprendizagem
- Destaque especial para as metodologias inovadoras
- Aulas teóricas, perguntas a especialistas, fóruns de discussão sobre temas controversos e trabalhos de reflexão individual
- Disponibilidade de acesso a todo o conteúdo a partir de qualquer dispositivo, fixo ou portátil, com conexão à Internet
Você oferecerá propostas inovadoras para melhorar o cuidado das principais condições cardiorrespiratórias crônicas”
O corpo docente deste curso inclui profissionais da área que transferem a experiência do seu trabalho para esta capacitação, além de especialistas reconhecidos de sociedades científicas de referência e universidades de prestígio.
O conteúdo multimídia, desenvolvido com a mais recente tecnologia educacional, permitirá ao profissional uma aprendizagem contextualizada, ou seja, realizada através de um ambiente simulado, proporcionando uma capacitação imersiva e programada para praticar diante de situações reais.
A estrutura deste programa se concentra na Aprendizagem Baseada em Problemas, através da qual o profissional deverá resolver as diferentes situações de prática profissional que surgirem ao longo do curso acadêmico. Para isso, contará com a ajuda de um inovador sistema de vídeo interativo realizado por especialistas reconhecidos.
Deseja se especializar na abordagem de usuários com Valvulopatias? Consiga isso em 6 semanas graças a este programa revolucionário”

Aproveite todos os benefícios da metodologia Relearning, a qual permitirá que você organize seu tempo e ritmo de estudo, adaptando ao seu horário”
Porquê estudar no TECH?
A TECH é a maior universidade digital do mundo. Com um impressionante catálogo de mais de 14.000 programas universitários, disponíveis em 11 línguas, posiciona-se como líder em empregabilidade, com uma taxa de colocação profissional de 99%. Além disso, possui um enorme corpo docente de mais de 6.000 professores de renome internacional.

Estuda na maior universidade digital do mundo e garante o teu sucesso profissional. O futuro começa na TECH”
A melhor universidade online do mundo segundo a FORBES
A prestigiada revista Forbes, especializada em negócios e finanças, destacou a TECH como «a melhor universidade online do mundo». Foi o que afirmaram recentemente num artigo da sua edição digital, no qual fazem eco da história de sucesso desta instituição, «graças à oferta académica que proporciona, à seleção do seu corpo docente e a um método de aprendizagem inovador destinado a formar os profissionais do futuro».
Um método de estudo inovador, um corpo docente de vanguarda e a sua orientação prática: a chave do sucesso da TECH.
Os planos de estudos mais completos do panorama universitário
A TECH oferece os planos de estudos mais completos do panorama universitário, com programas que abrangem os conceitos fundamentais e, ao mesmo tempo, os principais avanços científicos nas suas áreas científicas específicas. Além disso, estes programas são continuamente atualizados para garantir aos estudantes a vanguarda académica e as competências profissionais mais procuradas. Desta forma, os cursos da universidade proporcionam aos seus alunos uma vantagem significativa para impulsionar as suas carreiras com sucesso.
A TECH possui os planos de estudos mais completos e intensivos do panorama universitário atual.
O melhor corpo docente top internacional
O corpo docente da TECH é composto por mais de 6.000 professores de renome internacional. Professores, investigadores e quadros superiores de multinacionais, incluindo Isaiah Covington, treinador de desempenho dos Boston Celtics; Magda Romanska, investigadora principal do Harvard MetaLAB; Ignacio Wistumba, presidente do departamento de patologia molecular translacional do MD Anderson Cancer Center; e D.W. Pine, diretor criativo da revista TIME, entre outros.
Especialistas de renome internacional, especializados em vários ramos da Saúde, Tecnologia, Comunicação e Negócios, fazem parte do corpo docente da TECH.
Um método de aprendizagem único
Um método de aprendizagem único A ##UNIVERS IDAD_SIGLAS## é a primeira universidade a utilizar o Relearning em todos os seus cursos. É a melhor metodologia de aprendizagem online, acreditada com certificações internacionais de qualidade de ensino, fornecidas por agências educacionais de prestígio. Além disso, este modelo académico disruptivo é complementado pelo “Método do Caso”, configurando assim uma estratégia única de ensino online. São também implementados recursos didácticos inovadores, incluindo vídeos detalhados, infografias e resumos interativos.
A TECH combina o Relearning e o Método do Caso em todos os seus programas universitários para garantir uma excelente aprendizagem teórica e prática, estudando quando e onde quiser.
A maior universidade digital do mundo
A TECH é a maior universidade digital do mundo. Somos a maior instituição educativa, com o melhor e mais extenso catálogo educativo digital, cem por cento online abrangendo a grande maioria das áreas do conhecimento. Oferecemos o maior número de títulos próprios, pós-graduações e licenciaturas oficiais do mundo. No total, são mais de 14.000 títulos universitários, em onze línguas diferentes, o que nos torna a maior instituição de ensino do mundo.
A TECH conta com o mais extenso catálogo de programas académicos e oficiais do mundo e está disponível em mais de 11 línguas.
Google Partner Premier
O gigante tecnológico americano atribuiu à TECH o distintivo Google Partner Premier. Este prémio, que só está disponível para 3% das empresas no mundo, destaca a experiência eficaz, flexível e adaptada que esta universidade proporciona aos estudantes. O reconhecimento não só acredita o máximo rigor, desempenho e investimento nas infra-estruturas digitais da TECH, mas também coloca esta universidade como uma das empresas de tecnologia mais avançadas do mundo.
A Google colocou a TECH no top 3% das empresas tecnológicas mais importantes do mundo, atribuindo-lhe o distintivo Google Partner Premier.
A universidade online oficial da NBA
A TECH é a Universidade Online Oficial da NBA. Através de um acordo com a maior liga de basquetebol, oferece aos seus estudantes programas universitários exclusivos, bem como uma grande variedade de recursos educativos centrados no negócio da liga e noutras áreas da indústria desportiva. Cada programa tem um plano de estudos único e conta com oradores convidados excepcionais: profissionais com um passado desportivo distinto que oferecem os seus conhecimentos sobre os temas mais relevantes.
A TECH foi reconhecida pela NBA, a liga de basquetebol mais importante do mundo, como a sua universidade online oficial.
A universidade mais bem classificada pelos seus alunos
A Global score posicionou a TECH como a universidade mais bem avaliada do mundo pelos seus estudantes. Este portal de avaliação, o mais fiável e prestigiado porque verifica e valida a autenticidade de cada opinião publicada, atribuiu à TECH a sua classificação mais elevada, 4,9 em 5, com base em mais de 1000 avaliações recebidas. Estes números colocam a TECH como a referência universitária internacional absoluta. Estes resultados consolidam a TECH como uma instituição universitária de referência internacional, refletindo a excelência e o impacto positivo do seu modelo educativo”
A TECH é a universidade mais bem classificada pelos seus alunos no mundo.
Líderes em empregabilidade
A TECH conseguiu tornar-se a universidade líder em empregabilidade. 99% dos seus estudantes conseguem um emprego na área académica que estudaram, no prazo de um ano após a conclusão de qualquer um dos programas da universidade. Um número semelhante consegue uma melhoria imediata da sua carreira. Tudo isto graças a uma metodologia de estudo que baseia a sua eficácia na aquisição de competências práticas, absolutamente necessárias para o desenvolvimento profissional.
99% dos alunos da TECH conseguem emprego em menos de um ano após a conclusão dos seus estudos.
Curso de Patologias Cardiorrespiratórias no Paciente Crônico Complexo
Descubra a oportunidade de avançar em sua carreira médica com o nosso Curso de Patologias Cardiorrespiratórias no Paciente Crônico Complexo. Na TECH Universidade Tecnológica, oferecemos uma experiência educacional única que lhe permitirá adquirir conhecimentos especializados na área da medicina, com foco no tratamento abrangente de pacientes com doenças cardiorrespiratórias crônicas. Nosso programa é apresentado em um formato de ensino online, projetado para se adequar à sua agenda lotada e oferecer a flexibilidade de que você precisa. Com acesso a conteúdo educacional de alta qualidade de qualquer lugar, você pode avançar em seus estudos sem comprometer suas responsabilidades profissionais. Somos conhecidos por nosso compromisso com a excelência acadêmica e a capacitação de profissionais de destaque na área médica. Com este Curso, você estará imerso em um currículo que aborda de forma abrangente as complexidades da doença cardiorrespiratória em pacientes crônicos.
Capacite-se na melhor Faculdade de Medicina
Como aluno da TECH, você terá acesso a recursos de última geração e tecnologia de ponta que enriquecerão sua experiência de aprendizagem. Os professores especialistas na área o orientarão por meio de casos clínicos, estudos de caso e estágios que o prepararão para enfrentar desafios reais no ambiente médico. No centro do nosso programa está o foco em uma compreensão completa das patologias cardiorrespiratórias. Você aprenderá a avaliar, diagnosticar e tratar com eficácia pacientes com doenças crônicas, considerando aspectos como o gerenciamento de sintomas, a prevenção de complicações e o bem-estar geral do indivíduo que está sendo atendido. Após a conclusão bem-sucedida do Curso de Patologias Cardiorrespiratórias, você não apenas receberá um certificado endossado pela TECH Universidade Tecnológica, mas também estará preparado para se destacar em sua prática médica e contribuir significativamente para a saúde de pacientes com doenças cardiorrespiratórias crônicas. Dê o próximo passo em sua carreira médica e torne-se um especialista em medicina especializada!







